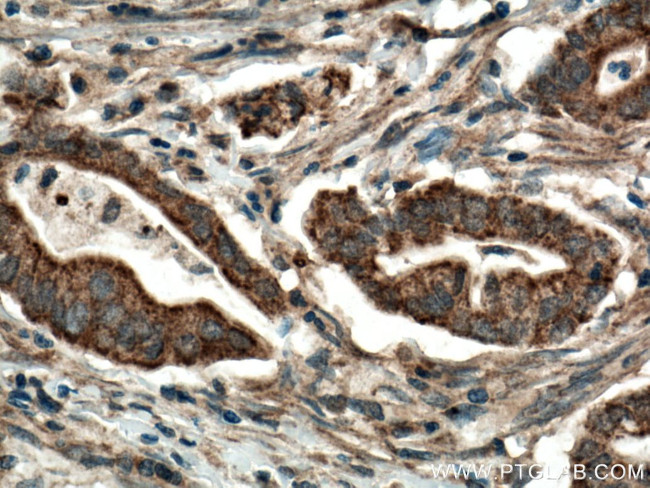
CDO1 Antibody in Immunohistochemistry (Paraffin) (IHC (P))
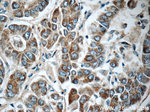
CDO1 Antibody in Immunohistochemistry (Paraffin) (IHC (P))

Search
Proteintech
CDO1 Polyclonal Antibody
{{$productOrderCtrl.translations['antibody.pdp.commerceCard.promotion.promotions']}}
{{$productOrderCtrl.translations['antibody.pdp.commerceCard.promotion.viewpromo']}}
{{$productOrderCtrl.translations['antibody.pdp.commerceCard.promotion.promocode']}}: {{promo.promoCode}} {{promo.promoTitle}} {{promo.promoDescription}}. {{$productOrderCtrl.translations['antibody.pdp.commerceCard.promotion.learnmore']}}
产品信息
12589-1-AP
种属反应
已发表种属
宿主/亚型
分类
类型
抗原
偶联物
形式
浓度
规格
纯化类型
保存液
内含物
保存条件
运输条件
产品详细信息
Immunogen sequence: MEQTEVLKP RTLADLIRIL HQLFAGDEVN VEEVQAIMEA YESDPTEWAM YAKFDQYRYT RNLVDQGNGK FNLMILCWGE GHGSSIHDHT NSHCFLKMLQ GNLKETLFAW PDKKSNEMVK KSERVLRENQ CAYINDSVGL HRVENISHTE PAVSLHLYSP PFDTCHAFDQ RTGHKNKVTM TFHSKFGIRT PNATSGSLEN N (1-200 aa encoded by BC024241)
靶标信息
CDO1 (cysteine dioxygenase, type I) belongs to the cysteine dioxygenase family and is involved in organosulfur biosynthesis. CDO1 functions as a dioxygenase that uses iron and zinc as cofactors to catalyze the conversion of L-cysteine and oxygen to 3-sulfinoalanine. CDO1 exists as a monomer and is expressed at high levels in liver and placenta and at lower levels in brain, pancreas and heart. CDO1 is involved in pyruvate-, sulfate- and taurine-related metabolic pathways and is a crucial regulator of cysteine concentrations within the cell.
仅用于科研。不用于诊断过程。未经明确授权不得转售。
生物信息学
蛋白别名: CDO; CDO-I; CDO1; CDOI; cysteine dioxygenase 1, cytosolic; Cysteine dioxygenase type 1; Cysteine dioxygenase type I; cysteine dioxygenase, type I; cytosolic cysteine dioxygenase 1; unnamed protein product
基因别名: 1300002L19Rik; Cdo; CDO-I; CDO1; D18Ucla3
UniProt ID: (Human) Q16878, (Rat) P21816, (Mouse) P60334
Entrez Gene ID: (Human) 1036, (Pig) 100312964, (Rat) 81718, (Mouse) 12583